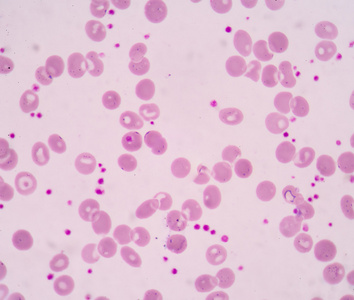
分割小血小板增多血涂片常用作照片

海因茨小体血涂片

溶血性贫血的血片与新生儿abo溶血的血片形态有什么不同
图片尺寸1080x1920
服用亚硝酸戊酯类药物时的血涂片.
图片尺寸437x413
图3:血小板卫星现象(edta盐所致,血常规数据中会出现假性血小板减少).
图片尺寸750x750
输血200ml后血涂片可见球形红细胞,豪乔氏小体,红细胞大小不等,且自体
图片尺寸528x300![[转载]血液镜检图片](https://imgs.wantubizhi.com/img/ADDA3C5D760C6828B77B505A29D43E830E5C0814C0C8908FE7CD76433B3958BC48C53D1B6E246B919622B68005C6E3FE115BD1E391E4258530FB0A048C2FD01E2721D234394A5FBF893F3BAA02B40AF89FE054D307773CA3D1F0E05BF86F5C88)
[转载]血液镜检图片
图片尺寸499x323
一种表面积与体积比增加的较薄细胞,正常人占1%--2%,常见于缺铁性贫血
图片尺寸750x562
4显微镜下抽血化验辨别红尿的特性:最先去尿里抽滤,假如由血细胞造成
图片尺寸418x399
血涂片镜检如下入院检查结果:wbc 16.85×109/l,rbc 1.
图片尺寸497x497
「血字研究」第二弹~|一页手册·协和八
图片尺寸428x276
猫狗体检省钱攻略把人民币花的明明白白
图片尺寸811x810
猫狗体检省钱攻略把人民币花的明明白白
图片尺寸788x817
周学习--巨幼细胞性贫血
图片尺寸1045x629
上海市松江区中心医院的夏万宝老师分享的10张外周血图片
图片尺寸800x600
卫健委临检中心2020年血细胞形态学检查室间质量评价及答案
图片尺寸1000x753
一例洋葱中毒继发免疫介导性溶血的病例分析
图片尺寸444x346
分割小血小板增多血涂片常用作照片
图片尺寸354x300
立即电话告知医生患者外周血涂片找到疑似异常早幼粒细胞,为了缩短
图片尺寸960x388
骨髓涂片瑞姬氏染色×1000检查意见:本次涂片示以粒系为主,有核细胞
图片尺寸653x435
不明原因皮肤瘀斑不可忽视!小心这种白血病
图片尺寸1080x1080
盔形红细胞(末梢血涂片)请报告箭头所指细胞的名称2018202椭圆形红
图片尺寸701x472




![[转载]血液镜检图片](https://imgs.wantubizhi.com/img/ADDA3C5D760C6828B77B505A29D43E830E5C0814C0C8908FE7CD76433B3958BC48C53D1B6E246B919622B68005C6E3FE115BD1E391E4258530FB0A048C2FD01E2721D234394A5FBF893F3BAA02B40AF89FE054D307773CA3D1F0E05BF86F5C88)
















![[转载]血液镜检图片](https://img.ph.126.net/xeVsfhNhrP-Q214aBc_UiQ==/3055410872194976100.jpg)